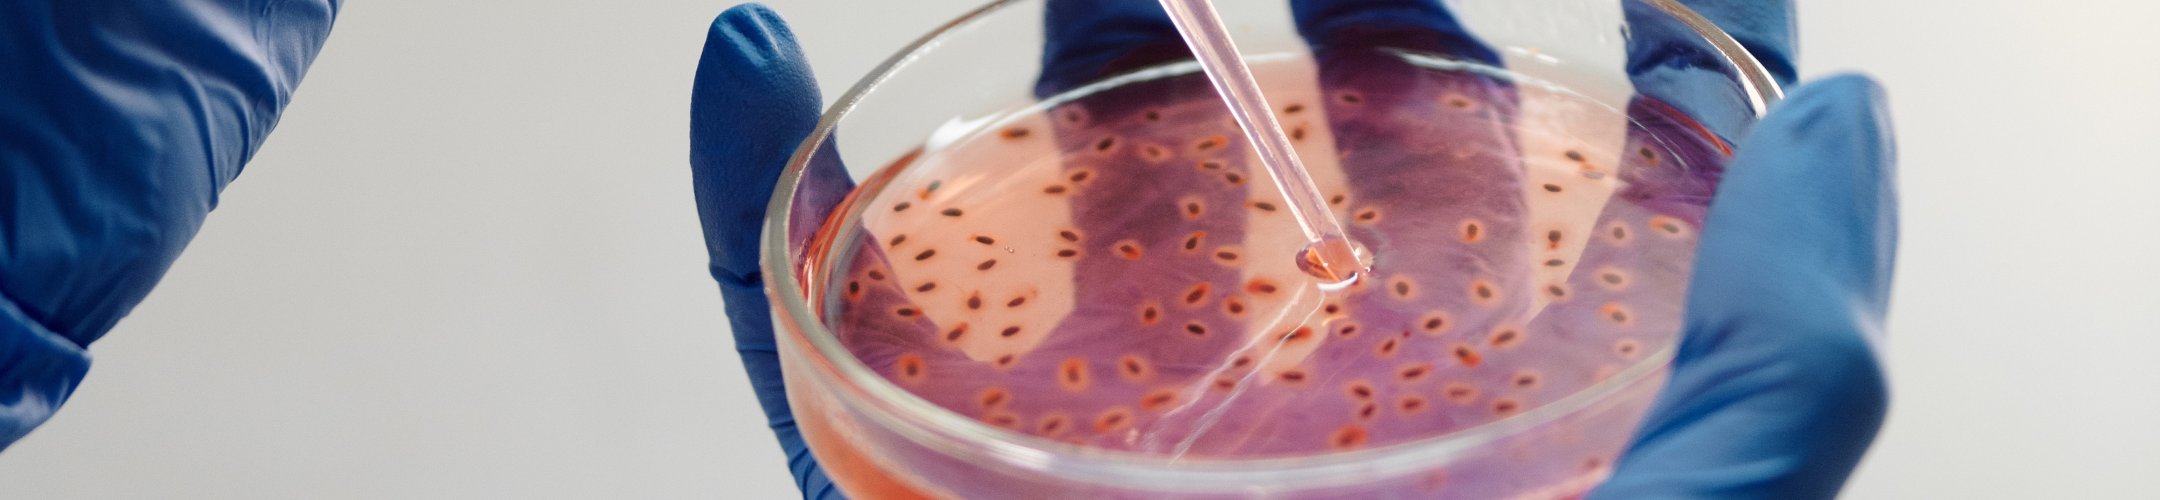
Minimising your administrative burden: EU registered collections

Als gebruiker van genetische bronnen kan het lastig zijn om informatie te verzamelen over de ABS-voorwaarden die gelden bij het verkrijgen en gebruiken van genetische bronnen. Wanneer u materiaal gebruikt uit een collectie die geregistreerd is onder de EU ABS Verordening, kunt u de administratieve lasten beperken en toch voldoen aan de ABS-regels.
De Europese Commissie houdt een lijst bij van collecties die geregistreerd zijn onder Artikel 5 van de EU ABS Verordening (Verordening (EU) 511/2014): het EU Register van Collecties. Deze collecties passen gestandaardiseerde procedures toe voor het aanleveren van genetische bronnen en daaraan gerelateerde informatie. De procedures zorgen ervoor dat, naast de genetische bron, alle relevante ABS-informatie aan derden wordt verstrekt, met documentatie waaruit blijkt dat toegang tot de genetische bronnen en daaraan gerelateerde informatie is verkregen in overeenstemming met de toepasselijke ABS-wetgeving en vereisten en, waar relevant, onder onderling overeengekomen voorwaarden (mutually agreed terms, MAT).
Het verkrijgen van genetische bronnen uit een geregistreerde collectie maakt het makkelijker voor gebruikers om te voldoen aan de ABS-wetgeving. Als u een genetische bron hebt verkregen uit een collectie die is opgenomen in het EU-Register van Collecties, wordt u verondersteld te hebben voldaan aan uw verplichtingen ten aanzien van passende zorgvuldigheid met betrekking tot het verzamelen van informatie (de informatie die vermeld staat in Artikel 4(3) van de Verordening). Het is echter mogelijk dat u wel een zorgvuldigheidsverklaring moet indienen. Meer informatie over zorgvuldigheidsverklaringen: ‘DECLARE of geen DECLARE: wanneer een zorgvuldigheidsverklaring indienen?’
U moet er wel rekening mee houden dat wanneer het beoogde gebruik verandert, het nodig kan zijn om nieuwe of bijgewerkte voorafgaande geïnformeerde toestemming (prior informed consent, PIC) van het land van levering te krijgen en nieuwe MAT vast te stellen voor het nieuwe gebruik, wanneer dit niet wordt gedekt onder de PIC en MAT die zijn verkregen door de geregistreerde collectie.
Waar vind ik het EU Register van Collecties?
Het EU Register van Collecties is te vinden op de ABS-webpagina van de Europese Commissie onder het kopje ‘Register of collections’. Het omvat momenteel collecties van het Leibniz-Institut DSMZ, de Franse Collectie voor Plant-geassocieerde Bacteria (CIRM-CFBP) en het onderzoeksinstituut Pierre Fabre.
Meer informatie over de geregistreerde collecties en hoe u hun genetische bronnen kunt verkrijgen is te vinden op de website van de Europese Commissie onder het kopje Register of Collections.
Deel:
